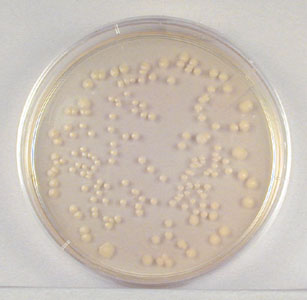
http://student.ccbc.cc.md.us/courses/bio141/labmanua/lab4/images/106.jpg
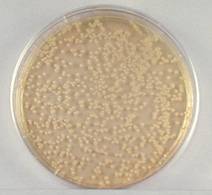
http://student.ccbc.cc.md.us/courses/bio141/labmanua/lab4/images/105.jpg

DISCUSSION
As part of daily routine, the laboratory microbiologist often has
to determine the number of bacteria in a given sample as well as having to compare
the amount of bacterial growth under various conditions. Enumeration (counting
of microbes in a sample) is especially important in dairy microbiology, food
microbiology, and water microbiology.
Since the enumeration of microorganisms
involves the use of extremely small dilutions and extremely large numbers of
cells, scientific notation is routinely used in calculations. A review of
exponential numbers, scientific notation, and dilutions is found in Appendix A.
THE PLATE COUNT (VIABLE
COUNT)
The number of bacteria in a given sample is usually too great to
be counted directly. However, if the sample is serially diluted (see Fig. 1)
and then plated out on an agar surface in such a manner that single isolated
bacteria form visible isolated colonies (see Fig. 2), the number of
colonies can be used as a measure of the number of viable (living) cells in
that known dilution.
However, keep in mind that if the organism normally forms multiple
cell arrangements, such as chains, the colony-forming unit may consist of a
chain of bacteria rather than a single bacterium. In addition, some of the
bacteria may be clumped together. Therefore, when doing the plate count
technique, we generally say we are determining the number of Colony-Forming
Units (CFUs) in that known dilution. By extrapolation, this number can in
turn be used to calculate the number of CFUs in the original sample.
FORMULAS AND INFORMATION YOU NEED TO KEEP IN MIND
![]()
![]()
![]()
Total = Previous Volume Transferred
Dilution Dilution New Total Volume
Plate Dilution = (Dilution in the test
tube) (Volume Transferred)
CFUs/ml = (Number of colonies on the
plate) (Dilution factor of the plate)
Dilution factor = inverse of the dilution
Only the plate with between
30 and 300 colonies is significant.
(In other words, you only count the colonies on the plate with 30-300
colonies.)
There are only 2
significant numbers. You report your
results in scientific notation.

Example: A plate containing a 1/1,000,000 (or 10-6)
dilution of the original ml of sample shows 150 colonies. 150 represents 1/1,000,000 the number of CFUs
present in the original ml. Therefore the number of CFUs per ml in the original
sample is found by multiplying 150 x 1,000,000 (or 106). In scientific notation, we would report that
as 1.5 x 108 CFUs/ml.
Recall our formula from the previous page…
CFUs/ml =
(Number of colonies on the plate)
(Dilution factor of the plate)
Our plate had 150 colonies and a dilution of 10-6. Therefore, our dilution factor = 106. So, our formula would be calculated as…
CFUs/ml = 150 x
106 = 1.5 x 108
OUR EXPERIMENT
We are going to imagine that we want to
determine the bacterial population count of a Tryptic Soy broth culture of Escherichia coli.
MATERIALS
·
Culture of E. coli
·
6 test tubes each containing 9.0 ml sterile water
·
3 sterile Petri dishes
·
liquid TSA cooled to 96°C,agar plates of TSA
·
7 sterile 5 ml pipettes
·
pipette pump
PROCEDURE
1. Aseptically dilute 1.0
ml of a sample of E. coli as shown in Fig. 1 and described
below.
a. Remove a sterile 5.0 ml
pipette (This is the 1st pipette you will use.) from the bag. Do
not touch the portion of the pipette that will go into the tubes and do not lay
the pipette down.
i. From the tip of the
pipette to the first line is 0.5 ml.
ii. The largest lines mark
whole milliliters.
iii. The medium lines mark 0.5
ml.
iv. The smallest lines mark
0.1 ml.
b. Insert the cotton-tipped
end of the pipette into a pipette pump.
c. Insert the pipette to the
bottom of the flask, and withdraw 1.0 ml of the sample by turning the
pipette pump knob.
i. Draw the sample up slowly
so that it isn't accidentally drawn into the filler itself.
d. Dispense the 1.0 ml of
sample into the first test tube of 9.0 ml of sterile water either by turning
the pipette pump knob or depressing the release trigger.
i. Draw the liquid up and
down in the pipette several times to rinse the pipette and help mix the diluted
solution.
e. Mix the tube thoroughly by holding the tube in one
hand and vigorously tapping the bottom with the other hand.
2. Insert
a sterile 5.0 ml pipette (This is the 2nd pipette you will use. Every time you draw from a new sample or test
tube, you need to use a new pipette.) into the pipette pump.
a. Using the same procedure,
aseptically withdraw 1.0 ml from the first dilution test tube and dispense into
the second dilution tube.
3. Insert
a sterile 5.0 ml pipette (This is the 3rd pipette you will use.)
into the pipette pump.
a. Using the same procedure, aseptically
withdraw 1.0 ml from the second dilution test tube and dispense into the third
dilution tube.
4. Insert
a sterile 5.0 ml pipette (This is the 4th pipette you will use.)
into the pipette pump.
a. Using the same procedure,
aseptically withdraw 1.0 ml from the third dilution test tube and dispense into
the fourth dilution tube.
5. Insert
a sterile 5.0 ml pipette (This is the 5th pipette you will use.)
into the pipette pump.
a. Using the same procedure,
aseptically withdraw 1.0 ml from the fourth dilution test tube and dispense
into the fifth dilution tube.
b. Using the same (the 5th)
pipette, aseptically withdraw 0.1 ml from the fourth dilution test tube and
dispense into the 1st sterile Petri dish.
6. Insert
a sterile 5.0 ml pipette (This is the 6th pipette you will use.)
into the pipette pump.
a. Using the same procedure,
aseptically withdraw 1.0 ml from the fifth dilution test tube and dispense into
the sixth dilution tube.
b. Using the same (the 6th)
pipette, aseptically withdraw 0.1 ml from the fifth dilution test tube and
dispense into the 2nd sterile Petri dish.
7. Insert a sterile 5.0 ml
pipette (This is the 7th pipette you will use.) into the pipette
pump.
a. Aseptically withdraw 0.1
ml from the sixth dilution test tube and dispense into the 3rd
sterile Petri dish.
8. Aseptically pour TSA into
the 3 Petri dishes.
a. Gently swirl the agar in
the dish.
b. Allow the agar to
solidify.
c. Place the dishes in the
incubator for 24 hours.
9. Calculate the CFUs/ml of
the sample.
RESULTS
Plate Count
1. Choose a plate that appears to have between 30 and 300
colonies.
This plate has over 300 colonies and cannot be used for counting.
We would record TMC (too
many to count) for this plate.
(Alternatively, some labs record TNTC – too numerous to count.)

This plate has between 30
and 300 colonies and is a suitable plate for counting.
(It
actually had 158 colonies. It is hard to
count this after it has been photocopied.)

This plate has less than
30 colonies and cannot be used for counting.
2. Count the exact number of colonies on that plate using the
colony counter (as demonstrated by your instructor).
3. Calculate the number of CFUs per ml of original sample as
follows:
CFUs/ml = (Number of colonies on the
plate) (Dilution factor of the plate)
Dilution factor = inverse of the dilution
There are only 2
significant numbers.
____________ = number of colonies
____________ = dilution factor of plate counted
____________ = number of CFUs per ml
After completing this lab, the student will be able to perform the
following objectives:
1. State the formula for determining the number of CFUs per ml of
sample when using the plate count technique.
2. When given a diagram of a plate count dilution and the number
of colonies on the resulting plates, choose the correct plate for counting,
determine the dilution factor of that plate, and calculate the number of CFUs
per ml in the original sample.

A sample of E. coli is
diluted according to the above diagram. The number of colonies that grew is
indicated on the Petri plates.
a. How many CFUs are there
per ml in the original sample?
b. What is the dilution in
the last test tube?
c. What is the dilution on
the plate with 3 colonies?
d. How many pipettes should
be used for this dilution?


10 ml 1 ml 10 ml 1 ml


10 ml 1 ml 0.1 ml


a. What is the dilution in test tube # 1?
b. What is the dilution in test tube # 2?
c. What is the dilution in test tube # 3?
d. What is the dilution in dish A?
e. What is the dilution in dish B?
f. What is the dilution in dish C?
g. How much water should there be in test tube #
4 for a total dilution of 10-7?
h. How many CFUs/ml did the E. coli sample have?
I. SCIENTIFIC NOTATION
When doing scientific calculations or writing, scientific
notation is commonly used. In scientific notation, one digit (a number
between 1 and 9) only is found to the left of the decimal point. The
following examples are written in scientific notation:
Note
that exponents (the powers of 10) are used in these conversions.
Multiples of 10 are expressed in positive exponents:
Fractions
of 10 are
expressed as negative exponents:
A. Procedure for converting numbers that are multiples of 10 to
scientific notation
1. Convert 365 to scientific notation.
·
Move the decimal point so that there is only one digit between 1
and 9 to the left of the point (from 365.0 to 3.65).
·
3.65 is a smaller number than the original. To equal the original
you would have to multiply 3.65 by 100. As shown above, 100 is represented by
102 . Therefore, the proper scientific notation of 365 would be 3.65
x 102 .
·
A simple way to look at these conversions is that you add a
positive power of 10 for each place the original decimal is moved to the left.
Since the decimal was moved two places to the left to get 3.65, the
exponent would be 102 , thus 3.65 x 102.
2. Convert 6,500,000 to scientific notation.
·
Move the decimal point so there is only one digit to the left of
the point (6,500,000 becomes 6.5).
·
To equal the original number, you would have to multiply 6.5 by
1,000,000 or 106. (Since you moved the decimal point 6 places to the left,
the exponent would be 106.)
·
Therefore, the proper scientific notation of 6,500,000 would be
6.5 x 106.
B. Procedure for converting numbers that are fractions of 10 to
scientific notation.
1. Convert 0.0175 to scientific notation.
·
Move the decimal so there is one digit between 1 and 9 to the left
of the decimal point (0.0175 becomes 1.75).
·
To equal the original number, you would have to multiply 1.75 by
0.01 or 10-2. Therefore, the proper scientific notation for 0.0175 would be
1.75 x 10-2.
·
A simpler way to look at these conversions is that you add a
negative power of 10 for each place you move the decimal to the right.
Since the decimal point was moved 2 places to the right, the exponent becomes
10-2, thus 1.75 x 10-2.
2. Convert 0.000345 to scientific notation.
·
Move the decimal point so only one digit (between 1 and 9) appears
to the left of the decimal (0.000345 becomes 3.45).
·
To equal the original number, you would have to multiply 3.45 by
0.0001 or 10-4. (Since you moved the decimal point 4 places to the right, the
exponent becomes 10-4.)
·
Therefore, the proper scientific notation of 0.000345 is 3.45 x 10-4.
C. Other examples
·
12,420,000 = 1.242 x 107
·
21,300 = 2.13 x 104
·
0.0047 = 4.7 x 10-3
·
0.000006 = 6.0 x 10-6
II.
Dilutions:
Examples
A. 1 ml of bacteria is mixed with 1 ml of sterile saline. The
total ml in the tube would be 2 ml, of which 1 ml is bacteria. This is a 1:2
dilution (also written 1/2, meaning 1/2 as many bacteria per ml as the original
ml).
B. 1 ml of bacteria is mixed with 3 ml of sterile saline. The
total ml in the tube would be 4 ml, of which 1 ml is bacteria. This is then a
1:4 dilution (also written 1/4, meaning 1/4 as many bacteria per ml as the
original ml).
C. 1 ml of bacteria is mixed with 9 ml of sterile saline. The
total ml in the tube would be 10 ml, of which 1 ml is bacteria. This is then a
1:10 dilution (also written 1/10 or 10-1, meaning 1/10 or 10-1 as many bacteria per ml
as the original ml).
D. For dilutions greater than 1:10, usually serial dilutions
(dilutions of dilutions) are made. The following represents a serial ten-fold
dilution ( a series of 1:10 dilutions):
|
|
|
|
The
dilution factor is the inverse of the dilution. (Inverse means
you flip the two numbers of the fraction; with scientific notation you use the positive
exponent.)
In other words, the dilution factor tells you what whole number
you have to multiply the dilution by to get back to the original 1 ml.